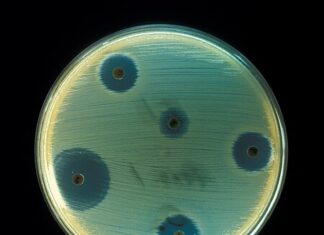
Un nou antibiotic care poate distruge bacteriile rezistente la medicamente, descoperit de oamenii de ştiinţă Antibiotic

Șofer arestat după ce a fost prins beat şi fără permis, de două ori...
Un bărbat în vârstă de 36 ani, din Sascut (Bacău), a fost arestat preventiv pentru 30 zile după ce a fost prins de poliţişti...
8 persoane rănite în urma unui accident grav produs în județul Sibiu
Un accident grav a avut loc, vineri dimineață, pe autostrada A1, la kilometrul 245, pe sensul de mers Sibiu-Sebeș, a anunțat ISU Sibiu. La...
Femeie din Vaslui reținută pentru conducerea fără permis
O femeie în vârstă de 33 de ani, din oraşul Negreşti, a fost reţinută de poliţişti după ce a fost depistată fără permis la...
12 cetățeni străini, găsiți ascunși printre cauciucuri, într-un TIR la Vama Nădlac
Mai multe persoane din Pakistan, Etiopia şi Afganistan au fost găsite ascunse printre cauciucuri transportate cu un TIR care urmă să iasă din ţară...
Adolescentă agresată în plină stradă, în Baia Mare
O adolescentă din Baia Mare a fost agresată în centrul orașului, chiar într-o stație de autobuz, de mai multe fete care au lovit-o brutal inclusiv cu...
Un ciclon de aer polar va afecta România
Aerul polar ajunge în România, începând de luni, 8 ianuarie, răcirea fiind una semnificativă. Elena Mateescu, director general al Administrației Naționale de Meteorologie (ANM)...
Dosar penal pentru un bărbat care i-ar fi încredințat fiului lui arma de vânătoare...
Poliţiştii au întocmit un dosar penal după ce un bărbat din localitatea Zemeş i-a încredinţat fiului său arma de vânătoare şi muniţia, a informat...
Un nou antibiotic care poate distruge bacteriile rezistente la medicamente, descoperit de oamenii de...
Oamenii de ştiinţă au descoperit o clasă complet nouă de antibiotice care pare să ucidă una dintre cele trei bacterii considerate a reprezenta cea...
Cornel Dinicu, patronul de la Ferma Dacilor, arestat pentru 30 de zile
Patronul de la Ferma Dacilor, Cornel Dinicu, a fost arestat pentru 30 de zile, au decis judecătorii Judecătoriei Ploiești. Cei doi administratori din acte de...
Vaccin pentru combaterea colesterolului, în curs de testare
Cercetătorii din Statele Unite au făcut progrese revoluționare în privința combaterii colesterolului. Un vaccin testat deocamdată doar pe animale a reușit să reducă nivelul...